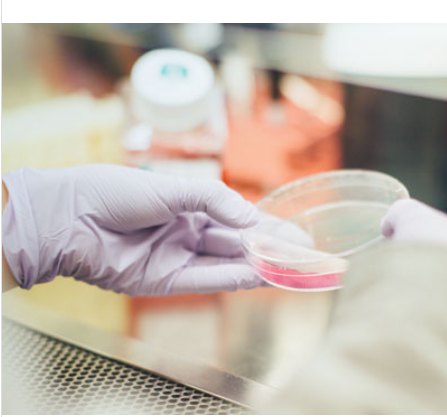
抗新冠病毒药物体外细胞毒性药效评价CC50检测

抗新冠病毒药物体外细胞毒性药效评价CC50检测
产品名称: 抗新冠病毒药物体外细胞毒性药效评价CC50检测
英文名称: CC50 determination in the in vitrocytotoxic evaluation of anti-SARS-CoV-2 drugs
产品编号: 006
产品价格: 1200
产品产地: 浙江杭州
品牌商标: null
更新时间: 2025-11-14T11:05:24
使用范围: null
| 规格 | 价格 |
| 个 | 1200.0 |
浙江迪福润丝生物科技股份有限公司
- 联系人 : 石女士
- 地址 : 浙江省杭州市滨江区长河街道滨安路688号2幢C楼6层601室
- 邮编 : 310053
- 所在区域 : 浙江省
- 电话 : 178****7374 点击查看
- 传真 : 点击查看
- 邮箱 : op@diff-biotech.com
- 二维码 : 点击查看
检测指标CC50:致50%细胞死亡所需的药物浓度,用以评价药物对细胞的毒性。
细胞系:非洲绿猴肾细胞系(VeroE6)
VeroE6是一种在不同实验室普遍用于培养SARS-CoV-2病毒并进行空斑分析的标准细胞系。[2]由于VeroE6细胞易受感染,饱和密度较低(最适空斑形成),且干扰素α和干扰素β分泌缺陷,所以将其用于病毒学研究较易观察到细胞病变现象。
检测周期:2~3周
实验方案:详询技术支持
